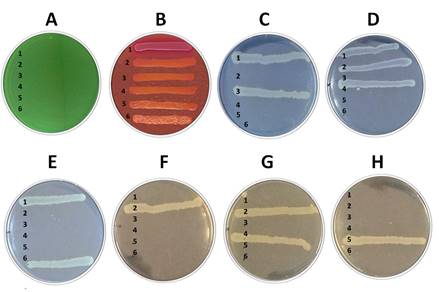

Resumen: Para las metodologías de ADN recombinante, los biólogos moleculares emplean mutantes de Escherichia coli que son adquiridos de kit comerciales o de colecciones microbianas especializadas. En la práctica estos mutantes son conservados por pases sucesivos o en un banco poco caracterizado. No seguir el sistema de lotes de siembra (lote de siembra de referencia y lotes de siembra de trabajo) y la falta de controles sistemáticos, puede llevar a la pérdida de las características originales de las cepas y afectar la calidad de los resultados experimentales. Por otra parte, la propia dinámica de los laboratorios de investigación hace que sea poco práctico realizar las extensas verificaciones propias del trabajo de las colecciones microbianas. El objetivo de este artículo es proponer un método de evaluación de pureza y estabilidad genética que permita la verificación de varios mutantes de E. coli en un solo ensayo. En él se definen los criterios de selección para el diseño de medios de cultivos específicos. Se realizan diluciones seriadas de los cultivos crecidos en medio Luria Bertani y se emplea como método de siembra las trazas de dilución. Los resultados evidencian que teniendo en cuenta las rutas metabólicas afectadas en cada mutante, se pueden agrupar varias cepas a verificar en un solo ensayo. La combinación de medios específicos permite tener un criterio de la pureza del cultivo y la estabilidad genética. Esta alternativa permite el chequeo rápido de aquellos marcadores de las cepas que son determinantes en las metodologías de ADN recombinante.
Palabras clave:Escherichia coliEscherichia coli, genotipo genotipo, ADN recombinante ADN recombinante.
Abstract: For recombinant DNA methodologies, molecular biologists use Escherichia coli mutants acquired from commercial kits or specialized microbial strain collections. These mutants are routinely conserved by successive passages or in poorly-characterized strain banks. A failure to follow the seed lot system (reference seed lot and working seed lot) and the lack of systematic controls, can lead to the loss of original strain characteristics and affect the quality of experimental results. On the other hand, the dynamic of research laboratories makes impractical to carry out extensive verifications related to the work with microbial collections. The aim of this article is to propose a single-assay method for genetic purity and stability evaluation of multiple E. coli mutants simultaneously. For the design of specific culture media, selection criteria were defined. Serial dilutions of cultures in Luria Bertani medium were made, and track dilution was used as seeding method. The results show how a mutated metabolic pathway-oriented design permit the verification of several strains in a single trial. A criterion about culture purity and genetic stability could be obtained after combining specific media. This alternative allows for a rapid evaluation of strain key genetic markers for recombinant DNA methodologies.
Keywords: Escherichia coli, genotype, recombinant DNA.
Artículos Originales
Método rápido de verificación de mutantes de Escherichia coli empleados en ingeniería genética
Rapid verification method of Escherichia coli mutants used in genetic engineering
Instituto Finlay
Recepción: 01 Febrero 2018
Aprobación: 01 Marzo 2018
La metodología de ADN recombinante requiere de una amplia variedad de mutantes de Escherichia coli que son comunes en los laboratorios de Biología Molecular. Muchas de estas cepas son derivadas de manipulaciones genéticas realizadas a partir de la década del 40 del siglo XX.(1)
El uso extendido de E. coli en este campo se debe a su fácil manipulación, su rápido crecimiento, el bajo costo de los medios de cultivo empleados para su propagación y el conocimiento acumulado de su bioquímica, fisiología, la dinámica poblacional y adaptación de su genoma. Estas cepas también son ampliamente utilizadas como hospederas para la expresión de proteínas recombinantes en los procesos biotecnológicos.(2,3)
Los experimentos de evolución adaptativa en el laboratorio con algunas de estas cepas de E. coli han demostrado la versatilidad de este microorganismo describiéndose un amplio número de mutaciones adaptativas.(4,5,6) Este fenómeno hace que la aplicación del concepto de sistema de siembra por lotes no sea suficiente para garantizar los genotipos originales de los mutantes. La pérdida del genotipo de interés se observa sobre todo en cepas donde es abolida la actividad de la enzima RecA del sistema de reparación de ADN, con una marcada disminución de la velocidad de crecimiento sobre medios sólidos agarizados.(7,8)
La Colección Central de Microorganismos del Centro de Ingeniería Genética y Biotecnología de La Habana (CIGB) ha desarrollado estrategias para la verificación de los bancos de mutantes de E. coli de importancia biotecnológica. Las metodologías combinan métodos moleculares y crecimiento en medios de cultivos selectivos.(9,10)
La combinación de los conceptos de Buenas Prácticas con diseños específicos de verificación, ha garantizado la estabilidad en el tiempo de los marcadores genéticos listados en los genotipos de las cepas de la colección. Sin embargo, estas metodologías que se establecen para los bancos de las colecciones microbianas son trabajosas y sobre todo, requiere de largos periodos de incubación. La propia dinámica de los laboratorios de investigación hace que sea poco práctico implementarlas como metodología de rutina.
El objetivo de este artículo es proponer un método de evaluación de pureza y estabilidad genética que permita la verificación de varios mutantes de E. coli en un solo ensayo. Esta evaluación se recomienda antes de abordar el trabajo molecular.
En el estudio se emplearon seis cepas de E. coli provenientes de la Colección Central de Microorganismos del CIGB (Tabla 1).
Características genotípicas de las cepas mutantes de E. coli

Para la verificación de las cepas se utilizaron los medios Luria-Bertani (LB) (triptona 10 g/L, extracto de levadura 5 g/L, cloruro de sodio 10 g/L)(11) y se suplementó con los antibióticos: tetraciclina, ácido nalidíxico o estreptomicina a 0,01 mg/mL. Los medios agar Mac Conkey No.3 y agar citrato de Simmons se prepararon según las recomendaciones del fabricante.(12)
Las placas con medio mínimo M9 se prepararon según Sambrook y colaboradores;(13) en todos los casos se suplementaron con glucosa 0,2% y se prepararon diferentes placas suplementadas con tiamina, o metionina a 0,02 mg/mL.
Para la verificación las cepas fueron inoculadas, a partir de bancos conservados a -80ºC, en tubos de ensayo que contenían 5 mL de medio LB suplementado con 0,2% de glucosa y crecidas a 37ºC durante toda la noche. Después del periodo de incubación se trasvasaron 50 µL a tubos eppendorf de 1,5 mL y se centrifugaron durante 15 min en una minicentrífuga de laboratorio, el sobrenadante se decantó y se resuspendió el precipitado en 950 µL de solución salina (NaCl 0,9%) empleando un vortex. De cada suspensión se sembraron 10 µL de las seis cepas en las placas con medios agarizados por el método de trazas de dilución.(14)
Para el diseño de los medios se definieron las rutas metabólicas afectadas empleando los recursos bioinformáticos de los sitios EcoCyc y ExPASy.(15,16) Las cepas se clasificaron en tres grupos según los marcadores genéticos para determinar los resultados esperados. Posteriormente se clasificaron los marcadores genotípicos, verificables por crecimiento en placa en: marcadores de vías anabólicas, vías catabólicas y genes de resistencia y se agruparon las cepas según el marcador diferencial que indica su identidad en los medios diseñados.
Las cepas de E. coli empleadas en metodologías de ADN recombinante son mutantes desarrollados en la primera mitad del siglo XX, en diferentes laboratorios de investigación.(1) Estas cepas son comercializadas por diferentes proveedores con una descripción de sus genotipos.
Diversos autores han reportado variaciones genotípicas de estas cepas de uso común en los laboratorios.(4,5) Las cepas de E. coli se utilizan como una herramienta en las metodologías del ADN recombinante, junto con otros materiales biológicos, como las enzimas de restricción o los plásmidos.(2,3)
Este hecho hace que los investigadores las empleen como un reactivo biológico más, no siendo una práctica común la verificación de su estabilidad o pureza. En este artículo se propone que se empleen como marcadores de identidad de las cepas algunos genes listados para discriminar la presencia de contaminantes con características similares asociados al cultivo.(9)
Teniendo en cuenta criterios sencillos de crecimiento en placas de medios selectivos o indicadores, se pueden evaluar de forma rápida varias cepas antes de abordar trabajos de clonaje y expresión de genes recombinantes. La selección de los marcadores más fáciles de evaluar, incluye genes de rutas catabólicas, genes de rutas anabólicas y genes de resistencia.
Aunque varias de las mutaciones hacen que una cepa sea ideal para la amplificación de plásmidos o para la expresión de proteínas recombinantes para la definición del ensayo y la selección de los medios de cultivo las cepas fueron clasificadas en tres grupos teniendo en cuenta los genes mutados (Tabla 2).
Clasificación de los marcadores genéticos de las cepas de E. coli

La selección de genes marcadores para una verificación rápida de la identidad de la cepa se basó en la comparación de cada una de ellas con el resto de las cepas seleccionadas. En el caso de las cepas XL1 Blue el requerimiento de tiamina en medio mínimo es un buen indicador debido a que tiene una alta frecuencia de reversión.
La DH5 α también requiere arginina para su crecimiento en medio mínimo. La cepa HB101 requiere leucina y prolina para crecer en medio mínimo y la LE392 requiere metionina. Una de las pruebas bioquímicas que tipifica los diferentes serotipos de la bacteria E. coli, es la capacidad de degradar lactosa como única fuente de carbono y energía. Muchas de las cepas de uso en Biología Molecular son incapaces de degradar la lactosa o la galactosa, por lo que esta propiedad puede ser seleccionada como un indicador de la no presencia de contaminantes cuando trabajamos con mutantes. La presencia de la mutación gyrA96 le confiere a las cepas DH5 α y XL1 Blue resistencia al ácido nalidíxico y el transposón Tn10 confiere resistencia a tetraciclina en la cepa XL1 Blue. La cepa HB101 muestra resistencia a la estreptomicina por la presencia de la mutación rpsL20. La selección de esta combinación de marcadores hace que puedan definirse medios donde el patrón de crecimiento sea diferente.
Para el ensayo de verificación se crecen precultivos de medio LB durante toda la noche El método de dilución traza es el método de siembra más económico ya que reduce notablemente el número de placas a utilizar. Con este método se siembran 10 µL sobre la superficie del medio y se deja correr la gota inclinando la placa. En cada placa se pueden colocar hasta 6 cepas (Fig. 1).

Fig. 1.
Estrategia de siembra en placa para la verificación simultánea de seis cepas de E. coli de uso común en el Laboratorio de Biología Molecular
La estrategia general de diseño de medios de cultivos indicadores, puede ajustarse teniendo en cuenta los genes marcadores comunes entre las cepas a verificar. Según el genotipo de las cepas se definieron ocho medios de cultivo diferentes: agar citrato de Simmons, agar MacConkey, medio M9 suplementado con glucosa, medio M9 suplementado con glucosa y tiamina, medio M9 suplementado con glucosa y metionina, medio LB suplementado con tetraciclina, medio LB suplementado con ácido nalidíxico y medio LB suplementado con estreptomicina, en los cuales se observan patrones diferentes de crecimiento (Fig. 2).

Fig. 2.
Patrón de crecimiento de las cepas de E. coli W3110 (1); XL-1 Blue (2); BL21(DE3) (3); DH5α (4); HB101 (5) y LE392 (6) en diferentes medios indicadores. A) ACS; B) AMC; C) M9 más glucosa 2 g/L; D) M9 más glucosa 2 g/L, más tiamina 0,02 mg/mL; E) M9 más glucosa 2 g/L, más metionina 0.02 mg/mL; F) LB más tetraciclina 0,015 mg/mL; G) LB más ácido nalidíxico 0,02 mg/mL, H) LB más estreptomicina 0,025 mg/mL.
La inclusión del medio agar citrato de Simmons se recomienda ya que las cepas de E. coli son citrato negativas, lo que ha sido empleado como una de las pruebas para el diagnóstico diferencial de enterobacterias en la clínica. Sin embargo, ha sido reportado que las cepas pueden adquirir la habilidad de crecer empleando el citrato como fuente de carbono.(7)
La presencia de la mutación en los genes estructurales del operón lactosa puede ser evidenciada en medios indicadores como el agar Mac Conkey o el agar Eosina azul de metileno. Las cepas mutantes no dan la coloración roja típica de E. coli salvaje. La pérdida de la capacidad de metabolizar lactosa, contrasta con las cepas de coliformes ambientales en todas las cepas seleccionadas para este estudio, a excepción de la W3110 y la BL21 (DE3). Sin embargo, esta última tiene afectada la vía de degradación de la galactosa por lo que tiene un comportamiento típico en medio agar Mac Conkey, observándose las colonias primero con una coloración roja que en pocas horas desaparece observándose las colonias blancas.
Cepas deficientes de la recombinación como la HB101, DH5 α y la XL1 Blue son empleadas ya que mejoran la estabilidad de inserción de genes heterólogos; sin embargo, esta característica hace que tengan también mayor frecuencia de mutación,(7) y sean más susceptibles al daño por la crioconservación.(7,8)
El establecer como rutina en el laboratorio esta metodología permite el chequeo rápido de aquellos marcadores de las cepas que son determinantes en las metodologías de ADN recombinante con lo que se garantiza una mayor calidad en los experimentos.
angela.sosa@cigb.edu.cu
Características genotípicas de las cepas mutantes de E. coli

Clasificación de los marcadores genéticos de las cepas de E. coli


Fig. 1.
Estrategia de siembra en placa para la verificación simultánea de seis cepas de E. coli de uso común en el Laboratorio de Biología Molecular
Fig. 2.
Patrón de crecimiento de las cepas de E. coli W3110 (1); XL-1 Blue (2); BL21(DE3) (3); DH5α (4); HB101 (5) y LE392 (6) en diferentes medios indicadores. A) ACS; B) AMC; C) M9 más glucosa 2 g/L; D) M9 más glucosa 2 g/L, más tiamina 0,02 mg/mL; E) M9 más glucosa 2 g/L, más metionina 0.02 mg/mL; F) LB más tetraciclina 0,015 mg/mL; G) LB más ácido nalidíxico 0,02 mg/mL, H) LB más estreptomicina 0,025 mg/mL.
